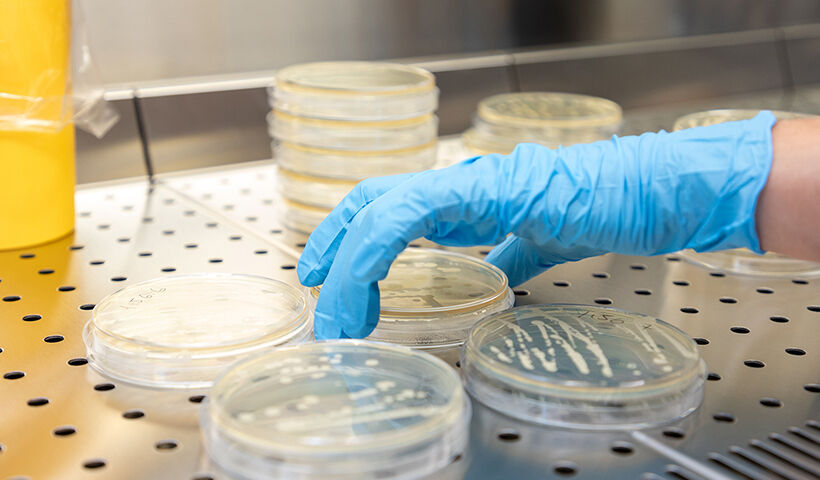

Food Sciences for Innovation and Authenticity
- Studienfeld(er): Ernährungswissenschaft, Lebensmittelchemie, Lebensmitteltechnologie, Qualitätsmanagement, Verpackungstechnik, Weinbau
- Startdatum: annually in the winter semester
- Regelstudienzeit: 4 Semester
- Studienform(en): Internationaler Studiengang, Vollzeitstudium
- Zulassungsmodus: Bachelor grades and language proficiency (English B2)
- Trägerschaft: Ausländische Hochschulen
- Hauptunterrichtssprache: Englisch
Course description
The course aims at training professionals who are able to work confidently in areas of food sciences, such as technology, engineering, microbiology, chemistry and sustainability.
Joint initiative with renowned partner universities:
After the first year, you can choose among four different profiles:
- Innovation and Authenticity of Wines (offered at unibz);
- Food Quality and Management (offered at University of Udine);
- Nutrition Sciences (offered at University of Parma);
- Food Chemistry (offered at University College of Cork, Ireland).
The last learning track is offered in partnership with the University College Cork, Ireland. Students will have the opportunity to spend up to two semesters in one of these European partner institutions.
The programme is supported by industries belonging to AssoImprenditori Alto Adige - sezione Alimentari - and Südtiroler Bauernbund - Unione Agricoltori e Coltivatori Diretti Sudtirolesi. This partnership will allow students to write their research thesis with joint tutorship from both the university and the food industry.
The course provides students with the tools to pursue a career as a consultant or to work in managerial roles, mainly in the food industries, and in companies that link the food supply chain, from manufacturing to storage and distribution, including large-scale retailers, and public and private centres dedicated to planning, managing and improving processes. Our graduates design and innovate all food processes and products to guarantee and enhance the sensory, nutritional and sustainable quality of the food chain.
Universitätsplatz 1
39100 Bozen
Tel: 0039 0471 012100
Fax: 0039 0471 012109
E-Mail: apply@unibz.it
In order to gain admission to this programme without the need for further verification you need an adequate knowledge of the basic disciplines of Mathematics, Chemistry, Physics and Biology and fundamental knowledge of the subjects preparatory to the fundamental disciplines of this degree class and a three-year bachelor degree.
A further requirement for admission is proof of level B2 in English.
- Schwerpunkte:
- Food Sciences, Enology, Food Quality, Nutrition Sciences, Food Chemistry, Food Microbiology, Food Industry
Early Bird Application: 03/03 - 06/05/2025 (by noon local time)
Late Application: 28/05 - 21/08/2025
Classes: from end of September to mid-June
Bemerkung:
EU citizens can apply for a scholarship granted by the Autonomous Province of Bozen-Bolzano- Zulassungssemester:
- annually in the winter semester
- Zulassungsmodus:
- Bachelor grades and language proficiency (English B2)
- Zugangsvoraussetzungen:
In order to gain admission to this programme without the need for further verification you need an adequate knowledge of the basic disciplines of Mathematics, Chemistry, Physics and Biology and fundamental knowledge of the subjects preparatory to the fundamental disciplines of this degree class and a three-year bachelor degree.
A further requirement for admission is proof of level B2 in English.
- Schwerpunkte:
- Food Sciences, Enology, Food Quality, Nutrition Sciences, Food Chemistry, Food Microbiology, Food Industry
Early Bird Application: 03/03 - 06/05/2025 (by noon local time)
Late Application: 28/05 - 21/08/2025
Classes: from end of September to mid-June
- Studienbeitrag:
- 1200 € per year
- Studienbeitrag (Bemerkung):
- EU citizens can apply for a scholarship granted by the Autonomous Province of Bozen-Bolzano
- Fakultät*:
- Faculty of Agricultural and Food Sciences
- Akkreditierung*:
- staatlich
Structure of the course
The first year mainly includes modules on Food Technology and Food Microbiology, which are common to all learning tracks.
From the second year onwards, modules become specific to the profile chosen and you will be able to choose from four profiles and a range of free choice courses to customize your study programme.